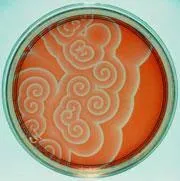
Image from Chemistry World

18 Experiments That Accidentally Created Life-Like Matter
These experiments demonstrate how simple chemistry can spontaneously create structures that mimic life.
- Alyana Aguja
- 5 min read
Throughout history, scientists have accidentally generated matter that exhibits life-like properties. From amino acids forming spontaneously to protocells that grow and divide, chemistry alone can simulate living processes. These findings provide insight into the origins of life and the boundary between chemistry and biology.
1. 1. The Urey-Miller Experiment

Image from NASA Astrobiology Program
In 1953, Stanley Miller and Harold Urey tried to recreate the conditions of early Earth. They passed electric sparks through a mixture of water, methane, ammonia, and hydrogen. Unexpectedly, they produced amino acids, the building blocks of proteins. The chemicals assembled in ways that mimicked early biological molecules.
2. 2. Spontaneous Formation of Microspheres by Sidney Fox

Image from Alchetron.com
In the 1960s, Sidney Fox heated dry amino acids to form tiny spherical structures. These microspheres could grow, bud, and exhibit cell-like behaviors. They were not alive but resembled primitive cells in form and function. This accidental creation demonstrated that physical conditions alone could generate life-like structures. Microspheres influenced later ideas about the origin of life.
3. 3. The Belousov-Zhabotinsky Reaction

Image from ResearchGate
Boris Belousov and Anatol Zhabotinsky accidentally discovered a chemical reaction that oscillates in color. The reaction created rhythmic, wave-like patterns that resembled life processes. It was surprising because it defied expectations of chemical equilibrium. This reaction mimicked metabolism without living cells. Researchers still study it as a model of self-organization.
4. 4. Self-Assembling Lipid Vesicles

Image from Creative Biolabs
In the 1970s, scientists found that when lipids were mixed in water, they spontaneously formed vesicles. These vesicles resembled cell membranes. The discovery was accidental during studies on detergents. They encapsulated chemicals inside, mimicking primitive cell compartments. This experiment offered clues to how early cells could have formed naturally.
5. 5. RNA World Catalysis by Thomas Cech

Image from BioNinja
Thomas Cech accidentally discovered that RNA could act as a catalyst in the 1980s. He observed that RNA molecules could splice themselves without proteins. This challenged the idea that only proteins could catalyze reactions. RNA acted in ways similar to enzymes, giving it a life-like function. The finding reshaped theories of how early life could self-replicate.
6. 6. The Pyrite Self-Organization Experiment

Image from MDPI
Researchers experimenting with metal sulfides noticed that pyrite crystals formed complex, organized patterns. These arrangements mimicked the appearance of microbial mats. They were not alive but suggested that mineral surfaces could guide molecular organization. The experiment showed that geological processes might contribute to life-like structures.
7. 7. Proteinoid Microspheres by Fox

Image from American Scientific Affiliation
Sidney Fox also discovered that when amino acids were heated, they formed proteinoid chains. In water, these chains assembled into microspheres that exhibited division-like behavior. This experiment was initially an attempt to study protein synthesis. The life-like properties were an unexpected outcome. These microspheres suggested mechanisms for the formation of primitive cells.
8. 8. Hydrothermal Vent Organic Synthesis

Image from Cambridge University Press & Assessment
Scientists simulating deep-sea hydrothermal vents accidentally produced amino acids and sugars. The high-pressure, high-temperature environment allowed molecules to self-assemble. The result resembled primitive chemical networks. This experiment implied that life-like chemistry could emerge without sunlight. Hydrothermal vents remain a key model for the origin of life.
9. 9. The Cairns-Smith Clay Hypothesis

Image from Prezi
Graham Cairns-Smith accidentally observed that certain clays could catalyze organic reactions. The crystals grew in patterns resembling primitive life scaffolds. Organic molecules stuck to the clay and organized in layers. This provided a potential template for prebiotic chemical evolution. Clay minerals offered a non-biological route to life-like structures.
10. 10. Self-Propagating Chemical Waves

Image from ACS Publications
In the 1980s, chemists observed that certain reactions created traveling chemical waves. These waves mimicked growth and movement. They were purely chemical but resembled the behavior of single-celled organisms. The discovery was unexpected during studies of oscillating reactions. It became a model for studying non-living life-like dynamics.
11. 11. Formamide-Based Nucleotide Formation

Image from MDPI
Researchers accidentally synthesized nucleobases by heating formamide with minerals. These compounds are the building blocks of RNA and DNA. The experiment was intended to study simple organic chemistry. The nucleotides formed spontaneously, suggesting prebiotic plausibility. This provided evidence for life-like molecules forming under natural conditions.
12. 12. Self-Assembling Peptide Nanotubes

Image from MDPI
In the 1990s, scientists found that short peptides could spontaneously form tubular structures. These nanotubes resembled cellular scaffolds. They were initially observed during protein folding studies. The structures exhibited compartmentalization similar to primitive life. Nanotubes offered insights into molecular organization without life.
13. 13. The Vortex Life-Like Droplets

David Becker from Unsplash
Chemists discovered that certain oil droplets in water would move and split spontaneously. The behavior was reminiscent of living cells dividing and swimming. It occurred by accident during experiments with surfactants. These droplets were entirely chemical yet mimicked motility. They are now studied as models for protocells.
14. 14. Autocatalytic Chemical Networks by Kauffman

Image from MDPI
Stuart Kauffman accidentally demonstrated that certain reaction networks could self-sustain. Molecules reinforced each other’s formation, mimicking metabolism. The networks were purely chemical with no life involved. They showed that chemistry alone can produce complex, life-like behaviors. This inspired theories on self-organizing life.
15. 15. Belousov-Zhabotinsky Droplets
Image from Chemistry World
When chemists placed BZ reactions inside tiny droplets, they began to oscillate and move. The droplets behaved like primitive cells, pulsing rhythmically. Movement emerged spontaneously without external control. This accidental result illustrated life-like dynamics in chemical systems. The findings influenced synthetic biology.
16. 16. Mineral-Catalyzed Fatty Acid Vesicles

Image from ScienceDirect.com
Fatty acids mixed with iron or other minerals formed vesicles accidentally. The vesicles were stable and could trap other molecules. They resembled cell membranes in structure. This hinted at mineral-mediated origins of compartmentalized chemistry. It supported models of protocell development on early Earth.
17. 17. Hydrogels Mimicking Tissue

Image from ScienceDirect.com
Researchers accidentally observed that polymer gels could swell, contract, and respond to stimuli. The hydrogels behaved like primitive tissue. They were initially developed for industrial purposes. The life-like responsiveness was unexpected. Hydrogels are now studied as analogs for artificial life.
18. 18. Synthetic Protocells by Szostak

Image from ScienceDirect.com
Jack Szostak accidentally discovered that fatty acid vesicles could encapsulate RNA and replicate under certain conditions. These protocells exhibited growth and division-like behaviors. The experiment revealed how chemical systems could mimic early cells. It bridged the gap between chemistry and life. These findings offered a roadmap for understanding prebiotic life.